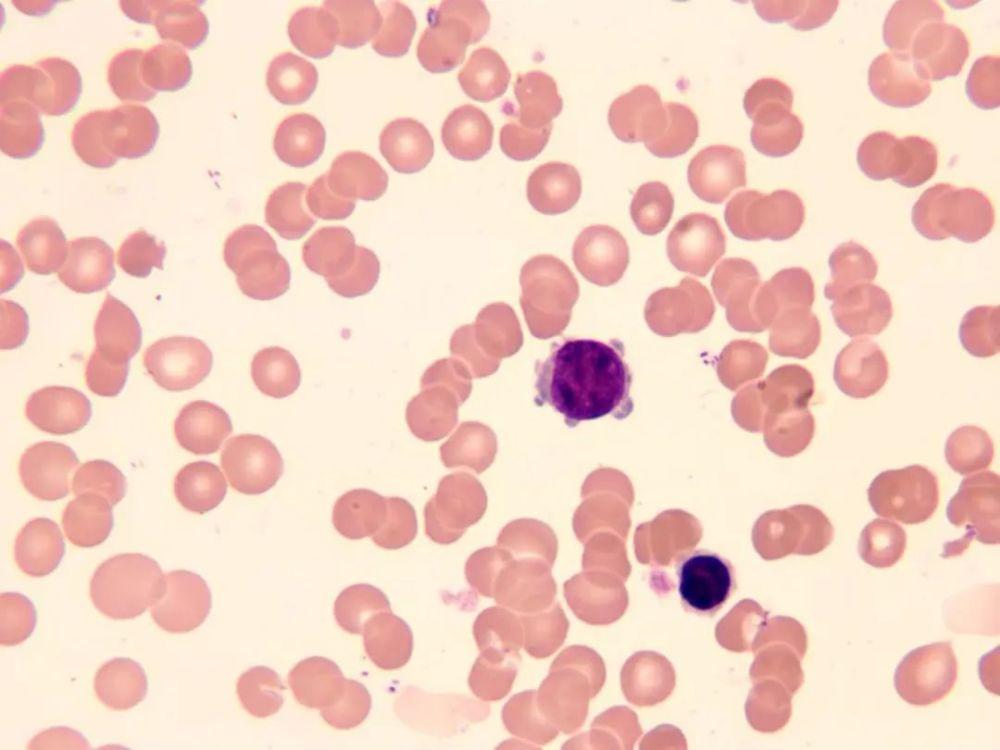
传染性急性单核细胞增多症,传染性单核细胞增多症有哪些

导语:感染性单核细胞增多主要是由 EB感染所致。发热、咽炎、淋巴结肿大是临床上典型的三联症,并伴有肝脾肿大、外周血淋巴细胞及淋巴细胞增生等。病程往往具有自限性的特点。大部分预后良好,少数可出现噬血细胞综合征等严重并发症。近距离口腔接触是传播此病的主要途径,如亲吻、共用餐具或咀嚼食物喂养婴儿等。

一、传染性单核细胞增多症,主要的发病原因是什么?临床表现有哪些?
1、什么是传染性单核细胞增多症?
感染性单核病是由 EBV (EbV)引起的一种急性传染病。
2、发病原因
乙型肝炎病毒是一种嗜淋巴 DNA病毒,属于疱疹病毒,主要侵入 b淋巴细胞(C3a受体与乙型肝炎病毒受体相同)。EBV含有5种抗原,均可产生相应的抗体:①壳抗原(VCA): VCA IgM抗体出现较早,1-2个月后就会消失,是 EBV近期感染的标志。VCA IgG出现较晚,但持续数年或终身,不能区分新旧感染。B早期抗原:是 EBV进入人类增殖周期初期形成的抗原,可分为分散组分 D和有限组分 R。该物质仅具有 EBV特异性 DNA聚合活性;该抗体可作为 EBV近期感染或活跃增殖的标志。
3、发病特征
该病在全世界都有发生,是分散的,并能引起小范围流行。每年都会生病,以秋至初春多病。感染源为病人和 EBV携带者。这种病毒在唾液腺和唾液中广泛存在,能连续或间歇解毒数周、数月甚至数年。传染途径主要是通过与口密切接触(口对应传播),有可能而非很重要的飞沫传播。输血和大便都能传染,在干燥的子宫里传染是个有争议的问题。该疾病以儿童和青少年多见,性别差异不显著,6岁以下儿童以隐性或轻度感染为主,15岁以后以典型症状为主。病程可获得持续免疫,二次发病罕见。

二、患有传染性单核细胞增多症,主要的临床表现有什么?检查方法有哪些?
1、临床表现
(1)本病潜伏期不定
疾病的潜伏期不确定,最多10天,儿童4-15天,青少年可达30天。大部分病人有不同程度的发热,一般在39℃左右波动,有时在40℃左右。发热持续一周左右,但中毒症状轻微。淋巴结病是该病的一个特点,所以也叫腺热病。浅表淋巴结可以累及全身。颈淋巴结肿大最常见,通常发生在第一周,第三周逐渐缩小。淋巴结一般散在无粘连,无压痛,无脓肿。当肠系膜淋巴结增大时,可以引起相应的腹痛等症状。大部分儿童咽痛,扁桃体肿胀,腔内可见白色渗出物,甚至能形成假膜。
(2)脾肿大
脾肿常发生在肋骨下2~3 cm处,伴有脾区疼痛或压痛。多数肝位于肋下2 cm内,常伴有肝功能异常,部分病人有黄疸。一些患者会出现不同类型的皮疹,如丘疹,黄斑,或类似的麻疹和猩红热。
2、检查方法
(1)血液检查
白细胞计数在血象病早期正常。白细胞总数常在发病后10~12天升高,高达30,000~60,000/mm3,在第三周则恢复正常。异常淋巴细胞可在发病第1~21天出现(10%~20%以上)。按细胞形态可分为泡沫型,不规则型和幼年型三种。这类异常细胞可能来自 T细胞,也有可能在其它病毒性肝炎中发现,如病毒性肝炎,出血性肝炎,水痘,腮腺炎等,但总体比例不到10%。血液计数会降低。大多数病人粒细胞缺乏或淋巴细胞减少,这可能与异常的免疫反应有关。

(2)骨髓象缺乏诊断
但是其它的疾病,比如血液病可以被排除。淋巴结可能异常(认为可能是外周血稀释所致)。核向左移,可见网状细胞增生;
(3)嗜异性凝集试验
异嗜凝集试验的阳性检出率为80%-90%,其依据是患者血清中常含有能凝集羊、马红细胞的 IgM凝胶抗体。平均体内抗体的持续时间是2-5个月。凝胶抗体随后出现的病人通常恢复得很慢。少量病例(约10%)异源凝集试验阴性,大多数为轻度,尤其是儿童。
可以通过豚鼠肾和牛血红细胞吸收试验来检测。对于正常人及以上所有患者(患者血清疾病除外),血嗜异抗体可被牛血红细胞完全吸收,或被该病患者血嗜异抗体部分吸收,而患者血清抗体则可完全吸收。特定凝集素滴度在1:50~1:224之间,一般认为大于80。若每周测量的效价增加超过4倍,效果就更明显。近几年来,用马红细胞代替羊红细胞的玻璃凝集实验,其速度和敏感性均优于试管法。
(4)EB病毒抗体测定
人源性 EB病毒可产生膜抗体、抗膜抗体、早期抗体、中和抗体、补体结合抗体、核结合抗体等。
(5)其他EB病毒培养
牛红细胞溶血素在血清中检测具有诊断价值(效价大于1:400)。抗 I抗体(I抗原只存在于胎儿细胞中)、抗核抗体等自身抗体在疾病急性期均可检测到。高滴度的冷凝剂对溶血性贫血有一定的抑制作用。
三、传染性单核细胞增多症,主要的治疗方法有一般治疗,以及药物治疗等
1、一般治疗
急诊室应卧床休息,加强护理,避免严重并发症的发生。脾明显增大时,应避免剧烈运动,以免破裂。抗菌素无效。如有继发细菌感染,可用抗生素。

2、药物治疗
(1)对症治疗
高热者可用退热药治疗。嗓子疼的人应该吃生理盐水漱口或者西瓜润喉片。对发热高、咽痛重的病人,要注意咽部继发细菌感染,咽拭子培养病要用抗生素。对心肌炎,重型肝炎,溶血性贫血,血小板减少和出血的病人,可以考虑使用糖皮质激素。
(2)抗病毒治疗
早期使用干扰素可减轻症状,减少口腔和咽喉内病毒排泄,但对潜伏 EB病毒感染无效。阿昔洛韦或 EB病毒特异性免疫球蛋白也可用于治疗。

3、预后
预后较好,病程一般为2-4周。有些病人在发病后会出现发热、淋巴结肿大、乏力等症状,可持续数周或数月。个别病例,病程可延长数年。死因是脾破裂,脑膜炎和心肌炎。
结语:咽部峡部溶血性链球菌感染可伴有30%的患者。急性性肾炎的发生率高达13%,临床表现与普通肾炎相似。脾脏破裂的发生率约为0.2%,通常在发病后10-21天出现。大约6%的病人会合并心肌炎。